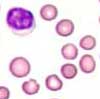

Kurzbeschreibung:
Die hereditäre Sphärozytose (HS) ist eine häufige, autosomal-dominant vererbte Krankheit, bei der die Erythrozyten durch Verlust von Membranoberfläche die typische Diskusform verlieren und eine Kugelform annehmen (Sphaere = griechisch Kugel). Die Krankheit ist charakterisiert durch eine unterschiedlich stark ausgeprägte, chronische Hämolyse, Retikulozytose und Splenomegalie. Die hereditäre Sphärozytose gehört in den Formenkreis der korpuskulären hämolytischen Anämien. Zugrunde liegen genetische Defekte verschiedener Proteine des Erythrozytenmebranskeletts (z.B. Ankyrin, Bande 3, beta-Spectrin). Durch Destabilisierung der Erythrozytenmembran kommt es zu Membranverlust, Abkugelung, verminderter Verformbarkeit der Erythrozyten und schliesslich zum vorzeitigen Abbau in der Milz.
Klinisches Bild:
Durch die verminderte Verformbarkeit werden die Erythrozyten in der Milz abgebaut (= Hämolyse). Als Folge wird die Milz vergrössert (= Splenomegalie). Je nach genetischem Defekt findet sich eine milde bis stark ausgeprägte Anämie. Durch Steigerung der Erythropoiese ist bei milden Formen das Hämoglobin manchmal sogar normal (kompensierte Hämolyse). Aufgrund der chronischen Hämolyse mit Bilirubinämie leiden die Patienten oft unter Bilirubin-Gallensteinen.
Infekte mit Parvovisrus B19 können die Erythropoiese für mehrere Tage unterdrücken. Bei Gesunden bleibt dies meist unbemerkt. Bei Patienten mit hämolytischen Anämien wie der HS kann dies aber zu einem dramatischen Abfall des Hämatokrits führen. Man nennt dieses Phänomen "aplastische Krise". Sie dauert in der Regel 7-10 Tage. Verschiedene, ansonsten banale Infekte der oberen Luftwege oder des Gastrointestinaltrakts können die hämaolytische Aktivität vorübergehend aggravieren. Man spricht in diesem Fall von "hämolytischen Krisen".
Diagnose und Therapie:
Die Diagnose erfolgt aufgrund der Klinik (Anämie, Ikterus, Splenomegalie), der Familienanamnese mit mehreren betroffenen Familienangehörigen, der hämolytischen Laborkonstellation (Retikulozyten, Bilirubin und LDH erhöht) und dem typischen Blutbild mit Sphärozyten. Zur Bestätigung dient die Messung der osmotischen Resistenz, welche bei der HS vermindert ausfällt. Der Test beruht auf der beschleunigten Lyse von HS-Erythrozyten in hypoosmolarem Milieu im Vergleich zur Erythrozyten von Gesunden. Weitere Tests zur Diagnose einer HS sind der saure Glycerol-Lysetest, der durchflusszytometrische Eosin-5-Maleinat-Bindungstest und die Ektazytometrie. Die Therapie der Sphärozytose besteht in der Splenektomie. Die Lebenszeit der Sphärozyten nimmt dadurch deutlich zu, normalisiert sich aber nicht ganz.
Hämatologie:
Die Erythrozyten sind rund, ohne zentrale Aufhellung und imponieren als Kugeln (Sphärozyten). Je nach klinischem Schweregrad ist das Hämoglobin normal oder leicht bis stark vermindert. Die Retikulozyten sind meistens erhöht. Aufgrund der Kugelform erscheinen die Zellen im Mikroskop kleiner. Das MCV und das MCH sind jedoch i.d.R. normal. Das MCHC ist typischerweise deutlich erhöht. Falls ein präanalytisches Artefakt ausgeschlossen werden kann, ist ein erhöhtes MCHC suggestiv für eine hereditäre Sphärozytose. Bei deutlicher Retikulozytose können das MCV und das MCH erhöht sein.
Knochenmark:

Eine Knochenmarksuntersuchung ist für die Diagnose einer hereditären Sphärozytose nicht notwendig. Das Knochenmark zeigt typischerweise eine gesteigerte Erythropoiese. Gelegentlich finden sich doppelkernige Proerythroblasten und Normoblasten.